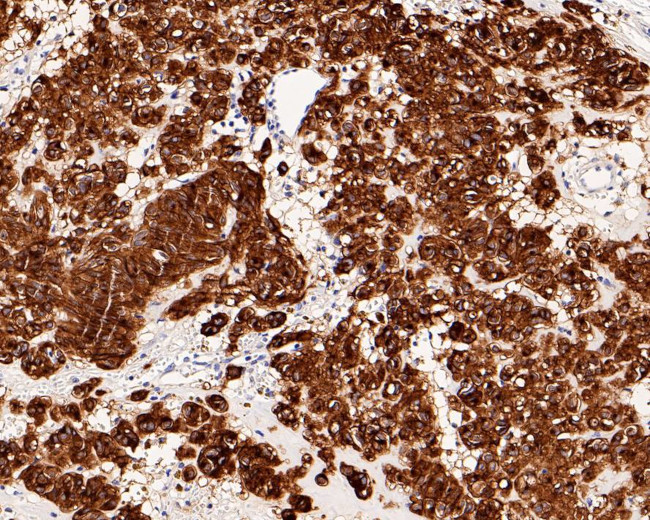
c-Kit Antibody in Immunohistochemistry (Paraffin) (IHC (P))

Search
Invitrogen
c-Kit Recombinant Rabbit Monoclonal Antibody (PD00-24)
{{$productOrderCtrl.translations['antibody.pdp.commerceCard.promotion.promotions']}}
{{$productOrderCtrl.translations['antibody.pdp.commerceCard.promotion.viewpromo']}}
{{$productOrderCtrl.translations['antibody.pdp.commerceCard.promotion.promocode']}}: {{promo.promoCode}} {{promo.promoTitle}} {{promo.promoDescription}}. {{$productOrderCtrl.translations['antibody.pdp.commerceCard.promotion.learnmore']}}
图: 1 / 5
c-Kit Antibody (MA5-50694) in IHC (P)





Please note: We are reviewing Western blot images included in the antibody testing data in our catalog, including those provided by third parties. Unless expressly labeled or annotated as “raw-unedited”, Western blot images included in the antibody testing data in our catalog may have been edited, optimized or otherwise adjusted for presentation.
产品信息
MA5-50694
种属反应
宿主/亚型
Expression System
分类
类型
克隆号
抗原
偶联物
形式
浓度
规格
纯化类型
保存液
内含物
保存条件
运输条件
RRID
产品详细信息
Positive control: Human seminoma tissue, human gastrointestinal stromal tumor tissue, human breast tissue, Saos-2 cell lysate, human lung tissue lysate, human cervical cancer.
Predicted band size: 110 kDa
Subcellular Location: Cell membrane; Cytoplasm.
靶标信息
KIT (c-KIT) is a proto-oncogene and a type 3 transmembrane receptor for MGF (mast cell growth factor, also known as stem cell factor). KIT was first identified as the cellular homolog of the feline sarcoma viral oncogene v-kit. KIT together with its ligand regulates growth and activation of a variety of hemopoietic and non-hemopoietic cells. Mutations in KIT are associated with gastrointestinal stromal tumors, mast cell disease, acute myelogenous leukemia, and piebaldism. Recently, deregulation of the KIT receptor TK by the prevalent activation loop mutation D816V has served as a focal point in therapeutic strategies aimed at curbing neoplastic mast cell growth. c-Kit is expressed in hematopoietic stem cells, germ cells, mast cells and gastrointestinal tract cajal cells. Upon binding of its ligand stem cell factor (SCF), c-kit dimerizes, resulting in receptor activation and autophosphorylation of various tyrosine residues including tyrosine 703 located on the cytoplasmic domain of the receptor. This modification allows docking of Grb2 and activation of the Ras/ERK signaling pathway. SCF/c-kit can activate multiple downstream signaling pathways including PI3K, PLC-gamma and JAK/STAT. c-kit receptor activation is essential for hematopoiesis, stem cell maintenance and gametogenesis.
仅用于科研。不用于诊断过程。未经明确授权不得转售。
篇参考文献 (0)
生物信息学
蛋白别名: CD117; ckit; Mast/stem cell growth factor receptor Kit; p145 c-kit; PBT; Piebald trait protein; Proto-oncogene c-Kit; SCFR; Tyrosine-protein kinase Kit; v-kit Hardy-Zuckerman 4 feline sarcoma viral oncogene homolog
基因别名: KIT; SCFR
Entrez Gene ID: (Human) 3815